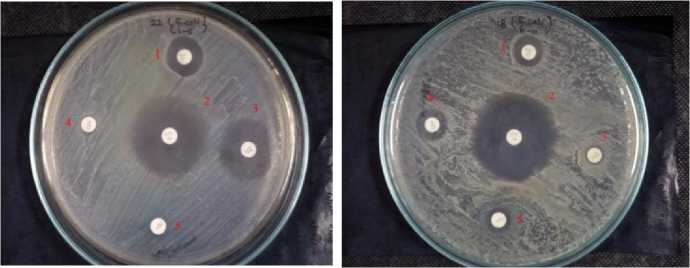

Kepekaan Eschericia coli Patogen yang Diisolasi dari Babi Penderita Kolibasilosis terhadap Antibiotik di Kecamatan Kerambitan dan Tebanan Kabupaten Tabanan, Bali
on
Jurnal Ilmu dan Kesehatan Hewan, Agustus 2013
Vol . 1, No. 2: 34-39
Kepekaan Eschericia coli Patogen yang Diisolasi dari Babi Penderita Kolibasilosis terhadap Antibiotik di Kecamatan Kerambitan dan Tebanan Kabupaten Tabanan, Bali
Sensitivity of Pathogenic E. coli Isolated from Pigs with Colibacillosis to Antibiotics at the District of Kerambitan and Tabanan, the Regency of Tabanan, Bali
Aditya Nugraha1, NK. Besung1, Hapsari Mahatmi1*
1 Laboratorium Mikrobiologi Veteriner FKH Universitas Udayana Jl. PB Sudirman Denpasar, Bali, Indonesia
*Corresponding author email: hmahatmi@yahoo.co.id
ABSTRACT
This study aims to determine the sensitivity pattern of E. coli isolated from pigs with colibacillosis to antibiotics. The total of 21 fecal samples was collected from pigs with white scour at the District of Kerambitan and Tabanan, the Regency of Tabanan, Bali. The isolation and identification of pathogenic E coli used Sheep Blood Agar medium, and serotype grouping of those bacteria was designated through agglutination test using serum’s antibody Polyvalent 1-5 and 6-11. The pathogenic E. coli found was then examined it`s own resistance to streptomycin, sulfamethoxazole, gentamicin, cefotaxime, and chloramphenicol according to Kirby Bouer method. The result showed that the isolates of E. coli polyvalent 1-5 were resistant to streptomycin and chloramphenicol, whereas that of polyvalent 6-11 was resistant to sulfamethoxazole, gentamicin, streptomycin and chloramphenicol.
Key words: E. coli, Polyvalent 1-5, Polyvalen 6-11, Colibacillosis, Pigs, White Scour, Antibiotics
ABSTRAK
Penelitian ini bertujuan untuk mengetahui pola kepekaan E. coli yang diisolasi dari babi penderita kolibasilosis terhadap antibiotik. Sebanyak 21 sampel feses diambil dari babi penderita menceret putih di Kecamatan Kerambitan dan Kecamatan Tabanan Kabupaten Tabanan. Isolasi dan identifikasi E. coli patogen menggunakan media Sheep Blood Agar, dan penentuan grup serotipenya melalui uji aglutinasi menggunakan serum antibodi polivalen 1-5 dan 6-11. E. coli patogen yang ditemukan selanjutnya diuji kepekaannya terhadap antibiotik streptomycin, sulfamethoxazole, gentamicin, cefotaxime, dan chloramphenicol dengan metode Kirby Bouer. Hasil penelitian menunjukkan bahwa isolat E. coli polivalen 1-5 resisten terhadap streptomycin dan chloramphenicol, sedangkan E coli polivalen 6-11 resisten terhadap sulfamethoxazole, gentamicin, streptomycin, dan chloramphenicol.
Kata kunci : E. coli, Polivalen 1-5, Polivalen 6-11, Kolibasilosis, Babi, Mencret Putih, Antibiotik
PENDAHULUAN
Kolibasilosis merupakan penyakit saluran pencernaan yang menyerang berbagai hewan dan bahkan beberapa serotipe berpeluang menjadi zoonosis. Penyebab kolibasilosis adalah bakteri Eschericia coli (E. coli ) strain patogen. Bakteri ini bersifat gram negatif, berbentuk batang, tidak berspora, fakultatif anaerob dan memfermentasi laktosa (Sornplang et al., 2010). Pada babi, kuman ini umumnya menginfeksi babi muda sebelum disapih atau setelah disapih dengan morbiditas mencapai 26 %, khususnya pada anak babi (Nagy and Fekete, 1999).
Penanganan kolibasilosis adalah dengan sanitasi yang baik dan pemberian antibiotik. Kesadaran dan pengetahuan peternak yang rendah terhadap pemakaian antibiotik akan berdampak buruk pada perkembangan resistensi kuman. Hal ini merupakan fenomena yang secara umum terjadi tidak hanya di Indonesia namun juga di Negara-negara berkembang lainnya, seperti yang dilaporkan oleh Schierack et al. ( 2009) bahwa 72,1 % sampel E. coli yang diisolasi dari lapangan resisten terhadap ampicillin, chloramphenicol, kanamycin, streptomycin, Sulfamethoxazole, dan tetracycline. Costa et al. (2010) melaporkan bahwa E. coli penyebab kolibasilosis pada anak babi di Negara Brazil sudah resisten terhadap ampicillin, trimethoprim, sulfamethoxazole, tetracycline, amikacine, colistin, norfloxacin, florfenicol, enrofloxacin, cefalexin, trimethoprim, neomycin, chloramphenicol, dan gentamicin. Hal serupa, hasil penelitian Sornplang et al. (2010) mengungkapkan bahwa isolat E. coli patogen yang diisolasi dari peternakan babi di Provinsi Khon Kaen, Thailand telah resisten terhadap penisilin, tetracycline, ampicillin, dan sulfamethoxazole.
Data tentang tingkat resistensi E. coli penyebab kolibasilosis pada babi sangat jarang di Indonesia, padahal informasi ini sangat penting untuk menentukan
kebijakan dan penanggulangan kasus kolibasilosis. Tujuan penelitian ini adalah untuk mengungkapkan tingkat resistensi isolat E. coli lapang penyebab kolibasilosis pada anak babi terhadap beberapa antibiotik di Kecamatan Kerambitan dan Tabanan, Kabupaten Tabanan, Propinsi Bali.
MATERI DAN METODE
Sampel Penelitian
Sebanyak 21 Sampel feses anak babi yang menderita mencret putih. dikoleksi menggunkan media transport amies. Sampel berasal dari petenakan tradisional dan peternakan semi intensif di
Kecamatan Kerambitan dan Kecamatan Tabanan Kabupaten Tabanan, Bali. .
Isolasi dan Identifikasi E. coli Patogen
Bakteri yang ada dalam feses dibiakkan pada media Mcconkey agar, dan diinkubasi pada suhu 37oC selama 18-24 jam. Koloni yang tumbuh dengan diameter sedang, berwarna merah bata atau merah tua, halus, dan sedikit cembung (ciri koloni E. coli, Bridson, 1998), selanjutnya dikelompokkan menjadi dua dengan uji aglutinasi menggunakan serum antibodi polivalen 1-5 dan polivalen 6-11 (Tabel 1, Biofarma, 2009). Butiran-butiran kecil yang terbentuk saat uji aglutinasi menadakan reaksi posisit. Untuk menentukan koloni E. coli patogen, kedua kelompok E. coli dibiakkan pada media Sheep blood agar (SBA). Koloni patogen dicirikan dengan adanya hemolisis pada media SBA.
Uji sensitivitas in vitro
Pola resistensi E. coli patogen terhadap antibitoka diuji menggunakan metode Kirby Bouer dengan mamakai cakram antibiotik, Suspensi E. coli patogen (mengandung 0,5 Standar McFarland = 1,5 x 108 sel) ditanam pada media Muller Hinton Agar (MHA), kemudian diinkubasi pada suhu 37oC . Setelah 15 menit atau
seluruh suspensi bakteri sudah terserap cakram antibiotik diletakkan ke dalam media dengan posisi satu cakram di tengah dan empat cakram mengelilinginya.
Selanjutnya, media diinkusbasi pada suhu 37oC selama 18 jam. Pola resistensi ditentukan berdarakan diameter zona hambat.
Tabel 1 Spesifikasi Serum Aglutinasi Untuk Diagnosa Polivalen O 1-5 dan O 6-11.
Polivalen 1-5 Polivalen 6-11
O1, O26, O86a, O111, O119, 127a, , O8, O15, O115, O169, O28ac , O112ac,
O128, O44, O55, O125, O126, O146 O124, O136, O144, O29, O143, O152,
O166, O18, O114, O142, O151, O157, O164
O158, O6, O27, O78, O148, O159, O168
O20, O25, O63, O153, O167
Sumber Biofarma, 2009
HASIL DAN PEMBAHASN
Hasil Penelitian
Hasil pemeriksaan menunjukkan bahwa dari 21 sampel feses, sejumlah 8 sampel positif mengandung E. coli
patogen. Dari 8 isolat E coli patogen, 7 isolat termasuk kelompok serotipe
polivalen 1-5 dan 1 isolat termasuk
kelompok serotipe polivalen 6-11.
Pola resistensi antibiotik ditunjukkan dengan adanya zona hambat di sekeliling cakram antibiotik. Variasi zona hambat antibiotik pada kelompok E. coli polivalen 1-5 ditampilkan pada Gambar 1a, dan kelompok E. coli polivalen 6-11 ditampilkan pada Gambar 1b. Hasil pengukuran diameter zona hambat kelompok E. coli polivalen 1-5 dan polivalen 6-11 ditunjukkan berturut-turut pada Tabel 2 dan 3.
a
b
Gambar 1 Variasi zona hambat antibiotik pada kelompok E coli polivalen 1-5 (a) dan polivalen 6-11 (b). 1. Sulfametoxazole (SXT), 2. Cefotaxime (CTX), 3. Gentamisin (GN), 4. Streptomisin (S), 5. Chloramphenicol (C)
Tabel 2 Hasil Uji Sensitivitas Antibiotik terhadap Kelompok E. coli Polivalen 1 – 5
No |
Antibiotik |
R |
I |
S |
Diameter hambat |
Interpretasi |
1 |
Sulfametoxazole (SXT) |
≤ 10 mm |
11-15mm |
≥ 16 mm |
16 mm |
Sensitif |
2 |
Cefotaxime (CTX) |
≤ 14 mm |
15-22 mm |
≥ 23 mm |
32 mm |
Sensitif |
3 |
Gentamisin (GN) |
≤ 12 mm |
13-14 mm |
≥ 15 mm |
22 mm |
Sensitif |
4 |
Streptomisin (S) |
≤ 11 mm |
12-14 mm |
≥ 15 mm |
7 mm |
Resisten |
5 |
Chloramphenicol (C) |
≤ 12 mm |
13-17 mm |
≥ 18 mm |
0 |
Resisten |
R: resisten; I: intermediet; S: sensitif
Tabel 3 Hasil Uji Sensitivitas Antibiotik Terhadap Serotipe Polivalen E. coli O 6-11
No |
Antibiotik |
R |
I |
S |
Diameter hambat |
Interpretasi |
1 |
Sulfametoxazole (SXT) |
≤ 10 mm |
11-15mm |
≥ 16 mm |
12 mm |
Intermediate |
2 |
Cefotaxime (CTX) |
≤ 14 mm |
15-22 mm |
≥ 23 mm |
37 mm |
Sensitif |
3 |
Gentamisin (GN) |
≤ 12 mm |
13-14 mm |
≥ 15 mm |
8 mm |
Resisten |
4 |
Streptomisin (S) |
≤ 11 mm |
12-14 mm |
≥ 15 mm |
13 mm |
Intermediate |
5 |
Chloramphenicol (C) |
≤ 12 mm |
13-17 mm |
≥ 18 mm |
10 mm |
Resisten |
R: resisten; I: intermediet; S: sensitif
Pembahasan
Isolat E. coli yang digunakan dalam penelitian ini adalah feses babi yang menderita penyakit kolibasilosis. Patogenitas E. coli dapat dikonfirmasi dengan sifatnya yang menghemolisis darah (alfa maupun beta) (Cavaleri et al., 1984). Dari 21 isolat yang diambil diperoleh tujuh isolat positif polivalen 1-5, dan satu isolat positif polivalen 1-6. Serum aglutinasi ini (polivalen1-5 dan 6-11) sangat umum digunakan untuk penentuan kelompok E. coli penyebab diare pada manusia, namun dalam komposisinya terdapat serotipe-serotipe tertentu yang sama dengan E. coli penyebab kolibasilosis pada babi.
Kolibasilosis pada babi dapat diobati dengan antibiotik yang bersifat bakteriostatik atau bakteriosidal. Namun, penggunaannya yang tidak tepat dapat menyebabkan resistensi bakteri terhadap antibiotik (Stephan and Schumacher, 2001). Sulfamethoxsazole, streptomycin, gentamicin, chloramphenicol, dan cefotaxim. adalah contoh kemoterapika atau antibiotik yang digunakan secara luas di lapangan.
Hail penelitian menunjukkan bahwa kedua kelompok E. coli (polivalen 1-5 dan 6-11) telah resisten terhadap steptomicin dan chloramphenicol (Tabel 2 dan 3). Hasil penelitian ini sejalan dengan yang hasil penelitian Wang et al. (2011) yakni 10 isolat E. coli dari berbagai serotipe telah resisten terhadap chloramphenicol, enrofloxacin, streptomycin, dan gentamisin. Di Ontario sebanyak 34% dari 55 isolat terbukti resisten terhadap streptomycin (Boerlin et al., 2005), sedangkan Bandyopadhyay et al. (2012) melaporkan bahwa 69% dari 75 isolat di
India telah resisten chloramphenicol. Akwar et al. (2008) mengemukakan bahwa penggunaan antibiotik seperti chloramphenicol dan streptomicyn sebagai growth promoter dalam pakan babi dapat mempengaruhi kejadian kasus resistensi.
Isolat E.coli polivalen 6-11 pada penelitian ini terindentifikasi multiresisten terhadap sulfamethoxazole, gentamicin, streptomycin, dan chloramphenicol. Hal serupa sebelumnya telah ditemukan oleh Suprat et al. (2011) bahwa sebanyak 15 isolat E. coli telah mengalami multiresisten terhadap streptomycin, lincomycin, gentamycin, tetracyklin, penisilin G, tiamuline, dan enrofloxasin. Wang et al. (2011) juga melaporkan bahwa sebanyak 10 isolat E. coli yang dimilikinya resisten ganda terhadap chloramphenicol, enrofloxacin, streptomycin, dan gentamisin. Semaraknya kasus resistensi bakteri terhadap antibiotik mungkin berkaitan dengan penggunaan antimikroba berspektrum luas dan penggunaan antimikroba dalam waktu yang panjang (McEwen and Fedorka-Cray, 2002). Kejadian resistensi antibotika mengakibatkan antibiotik tersebut tidak mampu menghambat atau membunuh bakteri sehingga pengobatan menjadi sia-sia (Besung, 2009). kecuali hanya meningkatkan residu antibotika yang sangat merugikan konsumen (Yuningsih, 2005). Adanya peraturan yang melarang penggunaan antibiotik pada campuran pakan sebagai growth promoter di Eropa (Castanon, 2007) dan China (Wang et al., 2011) para peneliti mulai memikirkan kemungkinan penggunaan bahan probiotik dan prebiotik untuk imbuhan dalam pakan (Haryati, 2011).
SIMPULAN
Kelompok E. coli polivalen 1-5 resisten terhadap streptomycin dan Chloramphenicol, sementara kelompok E. coli polivalen 6-11 resisten terhadap gentamicin dan chloramphenicol. Antibiotik generasi ke tiga dari golongan sefalosporin (Cefotaxime) masih mememiliki tingkat sensitifitas yang tinggi terhadap E coli patogen yang diisolasi dari Peternakan Babi di Kacamatan Kerambitan dan Tabanan, Kabupaten Tabanan, Bali.
UCAPAN TERIMA KASIH
Kepada Dirjen Dikti atas sebagian biaya dari Hibah Unggulan Perguruan Tinggi Universitas Udayana tahun 2011 melalui kepala proyek Dr. drh. Hapsari Mahatmi, MP.
DAFTAR PUSTAKA
Akwar HT, Poppe C, Wilson J., Richard J, Reid-Smith, Dyck M., Waddington J,. Shang D,. McEwen SA. 2008. Prevalence and patterns of antimicrobial resistance of fecal Escherichia coliamong pigs on 47 farrow-to-finish farms with different in-feed medication policies in Ontario and British Columbia. Can J Vet Res. 72(2) :195–201.
Bandyopadhyay S, Lodh C, Sarkar M,. Ghosh MK, Bera AK, Bhattacharyya D, Mondal DK, Baruah KK. 2012. Prevalence, molecular fingerprinting and drug resistance profile of enterovirulent Escherichia coliisolates from free ranging yaks of Tawang district, Arunachal Pradesh, India. Trop Anim Health Prod Vol 44, Issue 5 :1063–1072.
DOI:10.1007/s11250/011/0041/9. (http://link.springer.com).
Besung NK. 2009. Kejadian Kolibasilosis Pada Anak Babi. Majalah Ilmiah Peternakan. Vol 13, No 1 (2010) :1-7.
Boerlin P, Travis R, Gyles CL, Reid-Smith R, Janecko N, Lim H, Nicholson V, McEwen S A, Friendship R, Archambault M. 2005. Antimicrobial Resistance and Virulence Genes of Escherichia coli Isolates from Swine in Ontario. American Society for Microbiology. Vol. 71, No. 11. p. 6753–6761.
(http://www.ncbi.nlm.nih.gov/pmc/art icles/PMC1287655/pdf/0568-05.pdf).
Castanon JIR. 2007. History of the Use of Antibiotic as Growth Promoters in European Poultry Feeds. Poultry Science 86:2466–2471.
(http://ps.fass.org/content/86/11/2466. full.pdf)
Costa MM, Drescher G, Maboni F, Weber SS, Schrank A, Vainstein MH, Schrank IS, Vargas AC. 2010. Virulence factors, antimicrobial resistance, and plasmid content of Escherichia coli isolated in swine commercial farms. Arq.Bras. Med. Vet. Zootec, v 62 n.1, p.30-36, (http://www.scielo.br/pdf/abmvz/v62n 1/v62n1a04.pdf).
Haryati T. 2011. Probiotik dan Prebiotik Sebagai Imbuhan Pakan Non Ruminansia. WARTAZOA Vol. 21 No. 3 Th. 2011. p 125-132 (http://peternakan.litbang.deptan.go.id /fullteks/wartazoa/wazo213-4.pdf)
McEwen SA, and Fedorka-Cray PJ. 2002. Antimicrobial Use and Resistance in Animals. Clinical Infectious Diseases 2002; 34 (Suppl 3) :S93–106.
(http://www.ncbi.nlm.nih.gov/pubmed /11988879)
Nagy B, and Fekete PZ. 1999. Enterotoxigenic Escherichia coli (ETEC) in farm animals. Vet. Res. Vol: 30 : p 259–284. (http://www.vetres-archive.org/file/Vet.Res._0928-4249_1999_30_2-3_ART0007.pdf).
Schierack P, Kadlec K, Guenther S, Filter M, Schwarz S, Ewers C, Wieler LH. 2009. Antimicrobial resistances do not affect colonization parameters of intestinal E. coli in a small piglet group. Gut Pathogens 2009, 1:18; p 111.
(http://www.gutpathogens.com/conten t/1/1/18).
Sornplang PN, Na-ngam, and
Angkititrakul S. 2010. Antimicrobial Resistance Profile of Escherichia coli isolates From Fattening Pigs in Khon Kaen Province, Thailand.
International Conference on
Agriculture and Agro-Industry (ICAAI) 2010. Food,Health and Trade 19-20 November 2010. Pp 1-5.
(http://ora.kku.ac.th/RES_KKU/ATT ACHMENTS_PROCEEDING_PUBL ICATION/7832.pdf).
Stephan R, Schumacher S. 2001. Resistance patterns of non-O157 Shiga toxin-producing Escherichia coli (STEC) strains isolated from animals, food and asymptomatic human carriers in Switzerland. Lett. Appl. Microbiol. v.32, p.113-117.
DOI:
10.1046/j.1472/765x.2001.00867.x. (http://onlinelibrary.wiley.com).
Suprat AS, Pascu C, Costinar L, Vaduva I, Faur B, Tatar D, Herman V. 2011. Escherichia coli Strains
Characterization Isolated from PostWeaning Diarrhea in Pigs. Bulletin UASVM, Veterinary Medicine
68(2)/2011; p 286-289.
(http://journals.usamvcj.ro).
Wang XM, Liao XP, Liu SG, Zhang WJ, Jiang HX, Zhang M J, Zhu HQ, Sun Y, Sun J, Li AX, Liu YH. 2011. Serotypes, Virulence Genes, and
Antimicrobial Susceptibility of Escherichia coliIsolates from Pigs. Foodborne Pathogens and Disease. Vol 8, No 6. p 54-56.
(http://online.liebertpub.com/doi/pdfpl us/10.1089/fpd.2010.0739).
Yuningsih, 2005. Keberadaan Residu Antibiotika Dalam Produk Peternakan (Susu dan Daging). Loka karya Nasional Keamanan Pangan Produk Peternakan. Balai Penelitian
Veteriner.: 48-55
http://balitnak.litbang.deptan.go.id.
40
Discussion and feedback